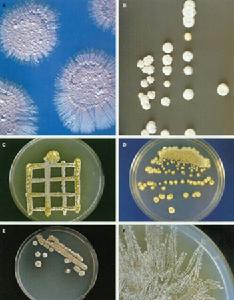
甲烷氧化菌

簡介
甲烷氧化菌,是以甲烷作為唯一碳源和能源進行同化和異化代謝的微生物,其關鍵酶之一是甲烷單加氧酶(MMOS),可以在氧氣的作用下催化甲烷等低碳烷烴或烯烴羥基化或環氧化。
環境中的甲烷在厭氧生境中由產甲烷細菌形成後,經土壤和水層,逸散入大氣,在途經土壤和水層時可被棲息於其間的甲烷氧化菌所氧化,土壤中甲烷氧化細菌的氧化作用,大約占大氣甲烷消耗量的10%。
甲烷
甲烷是一種對氣候有顯著變暖效應的溫室氣體,其增溫潛力值是二氧化碳的25倍。是以甲烷為其惟一的碳源和能源,在全球大氣甲烷平衡中起著重要的作用。甲烷含量的增長,引發了對甲烷來源和從大氣中清除過程的調查研究。
用途
而且甲烷氧化菌能降解鹵化碳氫化合物,具有潛在的商業價值。在自然界碳循環和工業生物技術中具有重要的套用價值。因此,對於甲烷氧化菌和MMOs的研究一直倍受生物學家的關注。
分型
甲烷氧化菌主要有甲烷氧化菌I型和II型,分別屬於α-變形菌綱(α-Proteobacteria)和β-變形菌綱(β-Proteobacteria),I型有甲基單胞菌(Methylomonas)、甲基球菌屬(Methylococcus)、Methylocaldum、甲基桿菌屬(Methylobacter)、甲基微菌(Methylomicrobium)和甲基熱菌屬(Methylothermus)等,II型有甲基彎曲菌屬(Methylosinus)、Methylocella、Methylocapsa和甲基孢囊菌屬(Methylocystis)等。
培養方法
甲烷氧化菌
甲烷氧化菌該方法是在常規培養甲烷氧化菌的培養基中添加脂肪酸。本發明具有以下優點:
1、脂肪酸受到機械力的作用形成微球,這些小球可以在氣相與菌體之間穿梭運動,從而源源不斷地將空氣中的甲烷直接供給菌體生長之用;
2、脂肪酸與菌體代謝物聯合作用產生極為穩定的微乳相,微乳相的增容作用有利於甲烷氧化菌的生長。
與常規培養方法相比,本發明的方法可以成倍地提高甲烷氧化菌的生長速度,最高達50倍。在用該方法對甲烷氧化菌進行固體平板培養時,不再需要頻繁地給固體平板補充甲烷氣體,菌體的生長速度也得到顯著提高。本發明將在甲烷氧化菌及其相關產品的工業化生產中發揮巨大作用,套用前景廣闊。
為獲得高效甲烷氧化微生物體系,從農業土壤中採樣,以甲烷作為唯一碳源進行好氧選擇性傳代培養,得到生長性能穩定、生長優於Methylosinus trichosporium OB3b純培養的具有甲烷單加氧酶(Methane Monooxygenase,MMO)活性甲烷氧化混合菌。
極地科考
氣候影響
 北冰洋中心海區儲存大量甲烷
北冰洋中心海區儲存大量甲烷2010年7月~9月,極地環境研究室的科研人員在參加中國第四次北極科考時,採用密閉箱法測定了北冰洋中心海域的甲烷通量(冰下海水每天每平方米的甲烷排放量)。
在該海域的海冰被打破後,甲烷呈現明顯的排放趨勢,冰下海水每天每平方米約平均排放0.56毫克甲烷,遠高於其他海域的海水甲烷通量,約為太平洋和大西洋的20倍以上。表明北冰洋中心海域的冰下海水中儲存著大量的甲烷氣體,海凍的存在阻礙了海水甲烷的排放。科研人員在海冰表面還觀測到負的甲烷通量,表明海冰表面存在吸收和消耗甲烷的過程。
2012年11月28日,科學家發現海冰消融將導致大氣中甲烷濃度增大。海冰中可能存在消耗甲烷的甲烷氧化菌,同時在海冰表面甲烷可以被光化學氧化消耗。該研究意味著氣候變暖將加速北冰洋海凍的消融,導致大氣中甲烷濃度增大,從而增強溫室效應。這又反過來進一步加速海冰消融,由此成為惡性循環。
